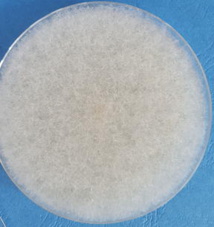
Absidia corymbifera Absidia corymbifera
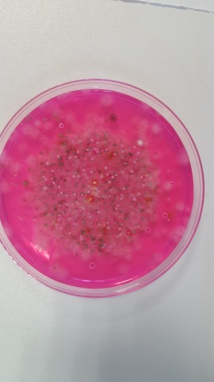
box en paille box en paille
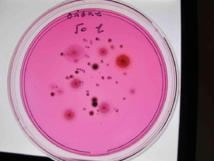
box en paille box en paille

Votre cheval tousse
Votre cheval commence à tousser , votre vétérinaire a fait un prélèvement trachéal en vue d'une analyse cytologique, bactériologique et mycologique des secrétions. Le laboratoire a ensemencé des boites de pétris spéciales pour rechercher des moisissures et levures. La culture ressemble a ce qui est montré sur la photo ci contre : il est temps de s’inquiéter de l'environnement de votre cheval avant que cette toux devienne chronique, et entraine une intolérance a l'effort.
Les moisissures
Les moisissures sont des champignons microscopiques qui poussent sur les aliments et les endroits humides. Ils produisent de très nombreuses spores qui sont plus ou moins volatiles. La paroi des moisissures est constituée de sucres (glucanes) qui ont un rôle pro-inflammatoire et irritant. Le cheval ayant de gros naseaux est particulièrement sensible aux spores de moisissures, chez l'homme la plupart des spores est arrêtée au niveau du nez. Les produits organiques volatils caractéristiques de l'odeur de champignon ont aussi un rôle irritant.
Certaines moisissures possèdent des protéines allergisantes responsables de toux chroniques.
D'autres ayant la capacité de se multiplier a 37°C peuvent être responsables de pathologies profondes graves : aspergillose pulmonaire ou aspergillose des poches gutturales.
Certaines moisissures possèdent des protéines allergisantes responsables de toux chroniques.
D'autres ayant la capacité de se multiplier a 37°C peuvent être responsables de pathologies profondes graves : aspergillose pulmonaire ou aspergillose des poches gutturales.
Differents groupes de moisissures
Il est important de connaitre la signification de la présence de différentes moisissures. Il est commode de les grouper en trois catégories.
Première catégorie : moisissures noires et fusarium
La première catégorie regroupe les pathogènes de plantes : ce sont ce que l'on appelle les champignons noirs( alternaria ,cladosporium...),et les fusarium. Ils sont apportés principalement par le foin , la paille et l'avoine, moins par l'orge ou le mais.
Le maximum dans la paille, le foin et l'avoine est inférieur à 200 000 spores/g,
Si certaines souches sont capables de pousser a 37°C elles peuvent coloniser les voies aériennes, et l'on peut voir a la fibroscopie des plaques noires qui sont des amas d'alternaria.
Alternaria peut provoquer des lésions ulcératives de la tête ou de l'encolure, et parfois entraine des lymphangites.
En plus de l'effet irritant de toutes les moisissures, alternaria et cladosporium possèdent des protéines allergisantes. Alternaria est considéré chez l'homme comme un allergène majeur.
Cladosporium peut etre responsable de pathologies cutanées chroniques , la contamination se fait lors d'une lésion chez des animaux immunodéprimés.
Les fusarium produisent des mycotoxines qui provoquent des intoxications alimentaires.
Le maximum dans la paille, le foin et l'avoine est inférieur à 200 000 spores/g,
Si certaines souches sont capables de pousser a 37°C elles peuvent coloniser les voies aériennes, et l'on peut voir a la fibroscopie des plaques noires qui sont des amas d'alternaria.
Alternaria peut provoquer des lésions ulcératives de la tête ou de l'encolure, et parfois entraine des lymphangites.
En plus de l'effet irritant de toutes les moisissures, alternaria et cladosporium possèdent des protéines allergisantes. Alternaria est considéré chez l'homme comme un allergène majeur.
Cladosporium peut etre responsable de pathologies cutanées chroniques , la contamination se fait lors d'une lésion chez des animaux immunodéprimés.
Les fusarium produisent des mycotoxines qui provoquent des intoxications alimentaires.
Deuxième catégorie: aspergillus et penicillium
Dans cette deuxième catégorie on va retrouver des moisissures qui sont les témoins de dégradation des aliments ou des litières. Il s'agit principalement des aspergillus et des pénicillium. Ces moisissures produisent de très nombreuses petites spores qui sont très volatiles.
Elles sont présentes normalement en quantité inférieure à 100 000 cfu/g dans le foin et la paille de bonne qualité, mais peuvent se multiplier dans la litière si celle ci n'est pas changée régulièrement. On peut en retrouver aussi sur les murs.
Elles sont présentes normalement en quantité inférieure à 100 000 cfu/g dans le foin et la paille de bonne qualité, mais peuvent se multiplier dans la litière si celle ci n'est pas changée régulièrement. On peut en retrouver aussi sur les murs.
Aspergillus
Les aspergillus se multiplient très vite , une spore peut en quelques jours produire plus de 10 000 nouvelles spores. Celles ci sont très volatiles car très hydrophobes. Pour les extraire du foin en milieux aqueux il faut rajouter un agent mouillant.
Les aspergillus qui on la faculté de se développer à 37°C sont potentiellement pathogène, et peuvent chez le cheval provoquer des infection des poches gutturales avec des hémorragies pouvant entrainer la mort. Cependant un aspergillus ne peut s'installer que sur de la fibrine d'une lésion pré-existante.
Dans l'ordre de virulence on peut citer : A.fumigatus,A.flavus, A.niger. Au laboratoire nous avons isolé un aspergillus flavus sur un oeil, malheureusement ce cheval a perdu son oeil.
Mais en dehors de ces cas dramatiques ces petites spores sont très irritantes et allergisantes.
Les aspergillus qui on la faculté de se développer à 37°C sont potentiellement pathogène, et peuvent chez le cheval provoquer des infection des poches gutturales avec des hémorragies pouvant entrainer la mort. Cependant un aspergillus ne peut s'installer que sur de la fibrine d'une lésion pré-existante.
Dans l'ordre de virulence on peut citer : A.fumigatus,A.flavus, A.niger. Au laboratoire nous avons isolé un aspergillus flavus sur un oeil, malheureusement ce cheval a perdu son oeil.
Mais en dehors de ces cas dramatiques ces petites spores sont très irritantes et allergisantes.
Penicillium
Les pénicillium comme les aspergillus produisent de très nombreuses petites spores très volatiles. Si on contrôle une balle de copeaux neuve , on trouve très peu de moisissures , sauf quelques pénicillium en nombre très faible. Cependant il semble que cela soit un bon substrat de culture pour ces moisissues dès qu'ils sont un peu humides. La question est donc de savoir combien de temps on peu les conserver dans un box avant qu'ils se multiplient de façon inquiétante.
Les spores sont très irritantes et peuvent provoquer des alvéolites.
Les spores sont très irritantes et peuvent provoquer des alvéolites.
Troisième catégorie : les mucorales et autres moisissures ayant besoin d'une forte humidité
Cette fcatégorie a besoin d'un taux d'humidité important pour se développer, Leur présence est normalement très faible dans le foin et la paille : moins de 5000 spores/g. Une quantité importante de spore indique un foin ou une paille avec un degré d'humidité trop important a la récolte. Il n'est pas rare d'en retrouver dans les lavages trachéaux de chevaux dont les box sont trop humides.
Ces moisissures sont parfois décrites comme cause de pathologies cutanées, gastro-intestinales et pulmonaires.
Ces moisissures sont parfois décrites comme cause de pathologies cutanées, gastro-intestinales et pulmonaires.
Mucorales
Les infections sont rarement décrites chez le cheval. Il s'agit le plus souvent de diagnostique post-mortem.On décrit des lésions cutanées, gastro-intestinales ou pulmonaire. Le plus souvent ces moisissures sont associées à d'autre agents pathogènes.
Geotrichum
Il s'agit d'une moisissure ressemblant à une levure. On l'isole parfois dans des lavages trachéaux. Elle peut être responsable de lésions cutanées principalement de la tête et de l'encolure. Cependant les cas décrits le sont chez des chevaux immunodéprimés.
Absidia corymbifera
La photographie montre une culture d'absidia corymbifera isolée dans un lavage trachéal; Cette moisissure a été décrite chez le cheval comme cause de lymphangite granulomateuse. D'autres cas ont été décrits de lésions de l'estomac, des intestins, du poumon et du cerveau.
On recherchera cette moisissure dans l'orge.
On recherchera cette moisissure dans l'orge.
Les prélèvements
Lavages trachéaux ou broncho-alvéolaires
Il ne s'agit pas vraiment de contrôler l'environnement, car la présence de nombreuses spores peut aussi bien révéler un environnement de mauvaise qualité qu'une altération de la clearance muco-ciliaire.
La présence de spores d'espèces potentiellement pathogènes ne suffit pas a affirmer la pathologie , il faut aussi voir des filaments mycéliens qui prouvent que les spores ont germé.
La présence de spores d'espèces potentiellement pathogènes ne suffit pas a affirmer la pathologie , il faut aussi voir des filaments mycéliens qui prouvent que les spores ont germé.
Prélèvements d'air : appareil a impaction
Un volume d'air est aspiré a travers les trous de l'appareil et les particules sont projetées sur une boite de pétri avec un milieux spécifique de ce que l'on cherche a énumérer.
Avantages : il n'est pas besoin d’ensemencer les boites au laboratoire, le choix des boites peut permettre de rechercher aussi des bactéries.
Inconvénient: si le volume prélevé est trop important il faut refaire le prélèvement. Délai de réponse d'au moins 7 jours après incubation
Avantages : il n'est pas besoin d’ensemencer les boites au laboratoire, le choix des boites peut permettre de rechercher aussi des bactéries.
Inconvénient: si le volume prélevé est trop important il faut refaire le prélèvement. Délai de réponse d'au moins 7 jours après incubation
Prélèvement d'air en milieux liquide
Un volume d'air est aspiré dans une centrifugeuse ou est placé un liquide. Les particules sont piégées dans le liquide.
Avantages: cela permet d'énumérer toutes les particule : poussieres, moisissures, pollens , bactéries et virus. cela ce prête à une analyse par PCR, donc résultats possibles dans la journée.
Inconvénients : il faut ensemencer manuellement les cultures et éviter le développement des moisissures pendant le transport. L'analyse par PCR ne permet de trouver que ce que l'on cherche.
Avantages: cela permet d'énumérer toutes les particule : poussieres, moisissures, pollens , bactéries et virus. cela ce prête à une analyse par PCR, donc résultats possibles dans la journée.
Inconvénients : il faut ensemencer manuellement les cultures et éviter le développement des moisissures pendant le transport. L'analyse par PCR ne permet de trouver que ce que l'on cherche.
Prélèvements de foin ou de paille
Il est nécessaire d'utiliser une sonde pour prélever dans les bottes, car ainsi le prélèvement est fait aussi bien en extérieur qu'a l'intérieur. Il faut prélever une dizaine d'échantillon qui seront mélangés pour analyse. Chaque prélèvement fait environ 10 grammes.
Exemple de numération
Voici un exemple de numération. Sur la premières boite le nombre de colonies est trop important pour etre compté.
Sur la deuxième boite on compte 30 colonies, ce qui représente 300 000 cfu/g , ce qui classe cette paille en grade 2.
Sur la troisième boite on compte 3 colonies , ce qui confirme le résultat.
Sur la deuxième boite on compte 30 colonies, ce qui représente 300 000 cfu/g , ce qui classe cette paille en grade 2.
Sur la troisième boite on compte 3 colonies , ce qui confirme le résultat.